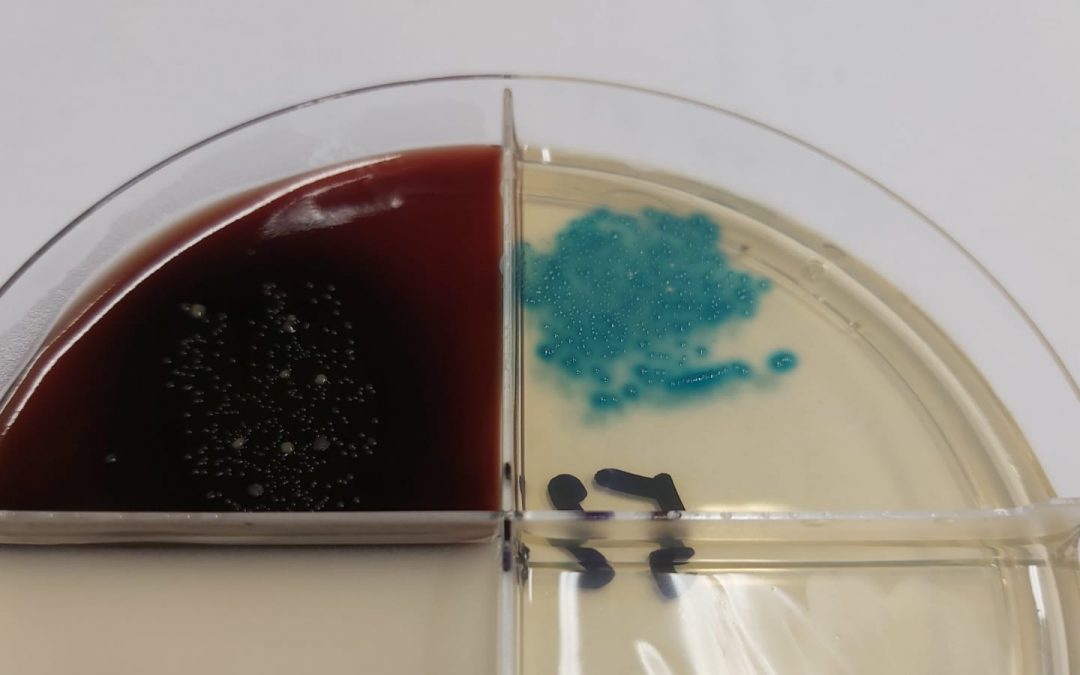
Ošetřujte správnou krávu ve správný čas

Rozhodnutí, zda krávu postiženou mastitidou bude nutné léčit antibiotiky není vždy snadné. Je důležité vzít v úvahu mnoho faktorů. Zvažte, zda je dojnice produktivním členem stáda a její případné šanci na vyléčení.
Rizikové faktory:
- Starší kráva
- Nízká produkce mléka
- Zhoršená reprodukce
- Souběžná jiná onemocnění – kulhání
- Chronicky se opakující mastitidy:
- Současná nebo předchozí diagnóza patogenů mastitidy, u nichž je nepravděpodobné, že se vyléčí – Staphylococcus aureus, Prototheca
- Tři nebo více předchozích případů klinické mastitidy v současné laktaci ( v rané fázi laktace zkontrolujte předchozí historii laktace )
- Více než 4 měsíce s vysokým počtem somatických buněk (> 200 000 buněk / ml)
Pokud má mít léčba smysl, nejlepším postupem je založit volbu léčby na patogenu působícím mastitidu. Některé patogeny nemusí léčbu vyžadovat, protože imunitní systém krávy může účinně odstranit infekci. Jiné patogeny však léčbu vyžadují a je důležité zvolit takovou, která bude pro patogen nejúčinnější na základě jeho citlivosti na antibiotika používaná v daném chovu.
Tématem stanovení citlivosti bakterií na antibiotika (tzv. antibiogram) a sestavením protokolu léčby pro daný chov se zabýval 3. webinář z celkové série 5 pokračování z cyklu online webinářů firmy FARMSYSTEM věnovaného cestě k neantibiotickému zaprahování ve smyslu cesty k trvale udržitelnému zdraví dojnic. Víte, jak vzniká rezistence na antibiotika nebo proč zvolená léčba nemusí být účinná? I to zaznělo na 3. webináři s tématem Antibiogram a protokol léčby na míru, který je možné shlédnout ZDE
Nestihli jste některý z webinářů? Shlédnout je můžete i ze záznamu na https://webinare.fasy.cz/
zdroj: https://www.dairyherd.com/news/treat-right-cow-right-time
foto: redakce

www.agropress.cz
www.agropress.cz


